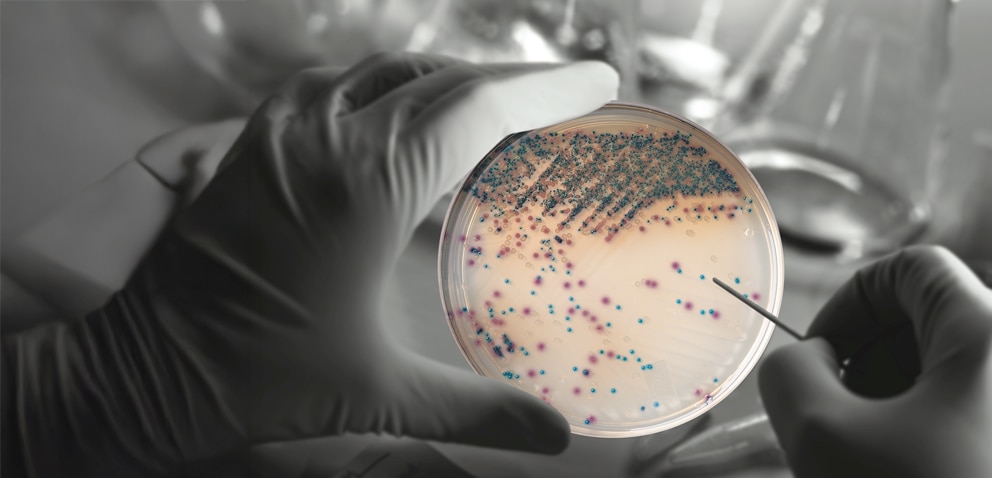
BD BBL CHROMagar Plated Media Hero Banner V5
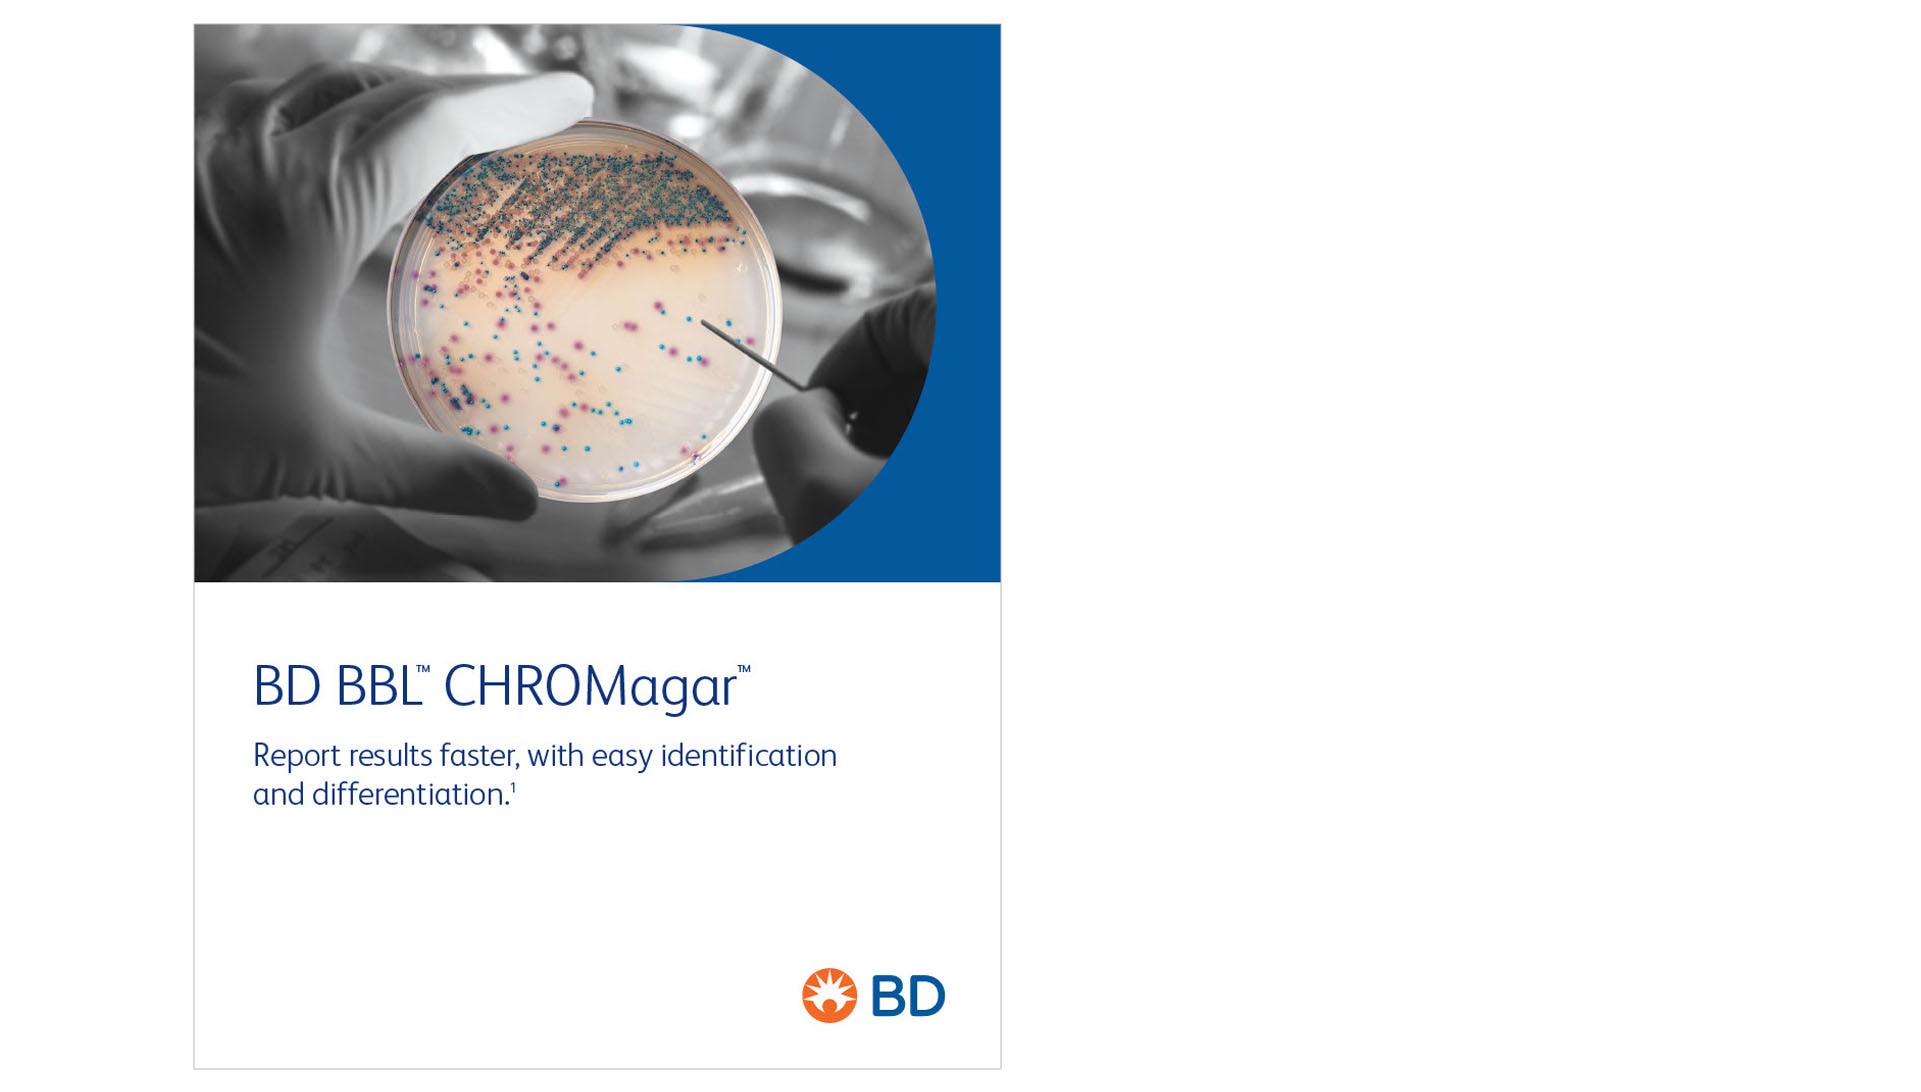
BD BBL CHROMagar brochure cover featuring the Orientation plate

We have manufactured high-quality BD BBL™ CHROMagar™ for microbiology laboratories for over 20 years.
The BD BBL™ CHROMagar™ family uses a chromogen mix that releases colored compounds after degradation by specific microbial enzymes. You can visually detect the bacteria by a distinct color change within the colony, so you can easily differentiate species with minimal confirmatory tests.8